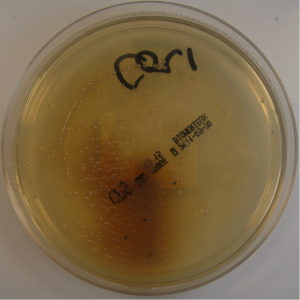

Urine infection is a big nuisance. It’s quite common in ladies, in view of the narrower urethra and the risk of ascending infection from the perineum. Especially, if it keeps coming back despite your common-sense preventative measures, then consult your doctor. The common sense methods, I recommend are, using non-perfumed toiletries, cotton underwear’s, shower instead of baths, cleaning from front to back, voiding after each sexual intercourse, drinking plenty of fluids, relieving yourselves often enough, avoiding the condoms, medicated diaphragms and spermicide contraceptives.
If still troubled, consult your doctor, who might suggest investigations as well as
- Start-stop antibiotic treatment – shelf self medications
- Low dose prophylactic antibiotics for a while
- Post coital antibiotics

